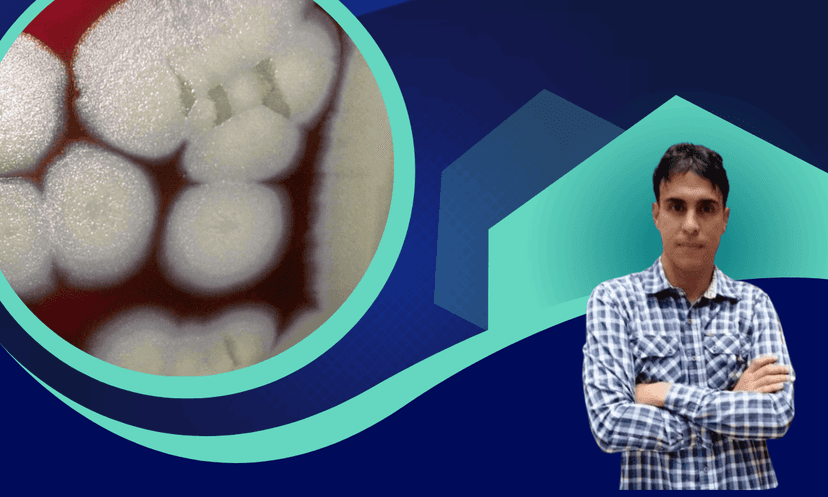
Imagen

Principios de fitopatología
Instructor
Hugo Enrique Rivera Arévalo
Fecha de inicio
sábado, 14 de febrero de 2026
11:00 p. m.
Descubre las ventajas exclusivas que obtendrás al completar este curso
Sesiones en vivo para resolver dudas y seguimiento personalizado de tu progreso académico.
Conexión con una comunidad global de científicos para debates, colaboración y desarrollo profesional.
Certificados emitidos por universidades reconocidas, validando tus conocimientos ante empleadores y colegas.
Disponibilidad 24/7 a los cursos, seguimiento de lecciones y descarga de recursos complementarios.

Obtenga una certificación reconocida por las empresas, la industria nacional y extranjera
Al finalizar el curso, recibirás un certificado de participación de flyteek
Si desea obtener certificación de la universidad, deberá adicionar el costo de la certificación
Instructor
Hugo Enrique Rivera Arévalo
Fecha de inicio
sábado, 14 de febrero de 2026
11:00 p. m.
Instructor
Doris Amanda Rosero García
Fecha de inicio
sábado, 7 de febrero de 2026
02:00 p. m.
Instructor
Hugo Enrique Rivera Arévalo
Fecha de inicio
sábado, 31 de enero de 2026
11:00 p. m.
Instructor
Audi Daniela Salcedo Pabon
Fecha de inicio
martes, 20 de enero de 2026
00:00 a. m.
Instructor
David Santamaría Jácome
Fecha de inicio
domingo, 18 de enero de 2026
00:30 a. m.
Instructor
Carolina Ramírez
Fecha de inicio
miércoles, 14 de enero de 2026
00:00 a. m.
Instructor
Laura Valentina Laverde Arias
Fecha de inicio
miércoles, 14 de enero de 2026
00:00 a. m.